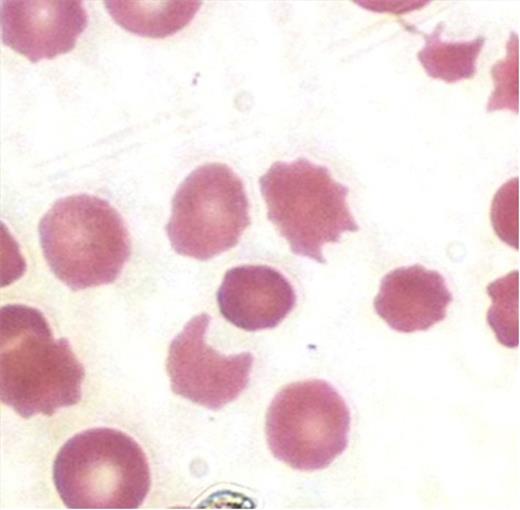
Figure 1.

Abstract
Introduction: Atypical hemolytic uremic syndrome (aHUS) is characterized by excessive complement activation within the microvasculature, resulting in a microangiopathic state resembling TTP and classic HUS. Until recently, it was considered rare, and related to familial abnormalities in genes encoding complement components. Prior to the advent of eculizumab, the overall prognosis was poor, with most progressing to end stage renal failure within three years of presentation. Here we will discuss an unusual case of deferasirox induced atypical hemolytic uremic syndrome in a patient with large granular lymphocytic leukemia (LGL) who had been requiring chronic transfusions secondary to anemia.
Case Presentation: Our patient is a 86 y.o. WM with a history of LGL requiring PRBC transfusions. Deferasirox, an iron chelating agent, was initiated when his ferritin rose to above 1000. Approximately one month later, he presented with generalized weakness, confusion, and abdominal pain over a two week period. Initial labs showed a creatinine of 3.99, Hgb 7.7 (baseline 9-10), platelet count 68, LDH 480, haptoglobin <15, with marked schistocytes on peripheral smear (below).
His renal failure, thrombocytopenia, and AMS were of new onset. Plasmapheresis was initiated for presumed TTP. Deferasirox was held because of the elevated creatinine. Initial and repeat values of ADAMTS-13 were normal, but his C3, C4, and CH50 levels remained consistently low. The patient had a good but incomplete response to dual volume plasmapheresis, and required continued daily treatment to maintain this improvement. With the continued consumption of compliment levels, the acute onset of a classical clinical picture, and a prolonged dependence on plasmapheresis, a clinical diagnosis of atypical hemolytic uremic syndrome (aHUS) was made. Plasmapheresis was subsequently stopped, and eculizumab was initiated. Almost immediately, his platelets and creatinine returned to baseline, both improving substantially over the values achieved on plasmapheresis. In addition, his hemolytic parameters as well as his mental status and overall feeling of well being improved. One week later, his C3 normalized. The patient was discharged and soon returned to living independently, driving, and exercising. Eculizumab was continued at a maintenance dose. A literature search identified no such association between deferasirox and aHUS, so this was dismissed as possibly having played a role in his presentation. Five months later, deferasirox was restarted. Within the next two weeks, the patient presented with relapsing aHUS with worsening renal failure, thrombocytopenia, anemia, and mental status changes. On this occasion, eculizumab was found to be ineffective even when the dosage was increased. The patient eventually opted against further treatment, and decided to pursue hospice. Both his eculizumab and deferasirox were discontinued. Surprisingly, within a few weeks, his mental status and labs improved, and the patient was able to leave hospice and return home. The strong temporal association with deferasirox, including relapse at re-challenge, led us to conclude that deferasirox was ultimately the cause of his aHUS.
Discussion:
In the last several years, the diagnosis of sporadic acquired aHUS has increased dramatically. This might be from a true increase in the incidence of aHUS, but it is more likely from patients previously diagnosed with TTP now being shifted to a diagnosis of aHUS. This, in turn, is likely due to the more widespread availability of the ADAMTS-13 assay, as well as the development of effective treatment for aHUS. In our patient, C3, C4, and CH50 levels were low, indicating that complement activation was involved. He also has LGL, a disease which NK or T cell regulated autoimmune response to hematologic precursors occurs; it is unknown whether this might predispose him to aHUS or to some undefined interaction with deferasirox. Nevertheless, our case does demonstrate a strong temporal relationship between the administration of deferasirox and aHUS. In the literature thus far, there has been no such documented association between the use of deferasirox and aHUS. As the incidence and recognition of aHUS increases, the list of secondary causes and drug associations will as well. Following this case study, we would add deferasirox to this list of possible etiologies.
No relevant conflicts of interest to declare.
Author notes
Asterisk with author names denotes non-ASH members.
This feature is available to Subscribers Only
Sign In or Create an Account Close Modal